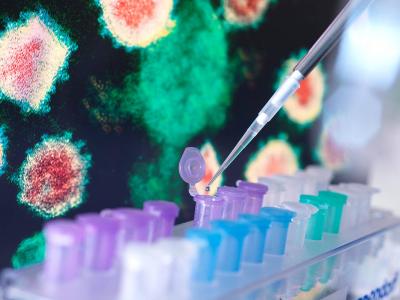

Az Északi-sarkvidékről 4000 kilométerre délre sodródott palackpostát talált két ír szörfös – írta a BBC hírportálja. Mint kiderült, a fémtartály orosz sarkkutató hajón utazók időkapszulája volt. A kapszula útja az ír partoknál, Gweedore-nál végződött.
Sophie Curran és Conor McClory, akik rábukkantak, A palack 2018-ból származó leveleket, fotókat és egyéb relikviákat találtak a palackban a világ második legnagyobb jégtörőjén, a 50 let pobjedi (a győzelem 50 éve) nevű hajó fedélzetén utazóktól.
Az orosz jégtörő, amely 2,5 méter vastag jeget is át tud törni, és óránként 20 kilométeres sebességgel halad a nyílt vízen, turistákat is visz az Északi-sarkra. A fedélzetén 140 főnyi legénységet és személyzetet, valamint 128 vendéget tud szállítani.

A levelek közül kettőt angolul írtak, de még így is eltartott egy ideig, amíg kiderült, hogy honnan származik az időkapszula. A kutatásban a közösségi média volt a megtalálók segítségére, mivel sikerült felvenniük a kapcsolatot egy szentpétervári bloggerrel, aki az egyik levelet írta. Szveta elmesélte, hogy a kapszulát az Északi-sarkvidék jegébe süllyesztették a 2018-as expedíción, de valószínűleg kiolvadhatott, és két év alatt jókora utat tett meg. A bloggert alaposan meglepte, hogy ilyen hamar előkerült a kapszula, mivel arra számított, hogy 30-50 évbe is beletelhet, míg valaki megtalálja.
A szörfösök és a blogger viszont jó barátságba kerültek, és elhatározták, hogy amint a járvány után lehetséges, találkoznak és együtt szörföznek az írországi Donegal megye partvidékén, ahol a kapszula előkerült.